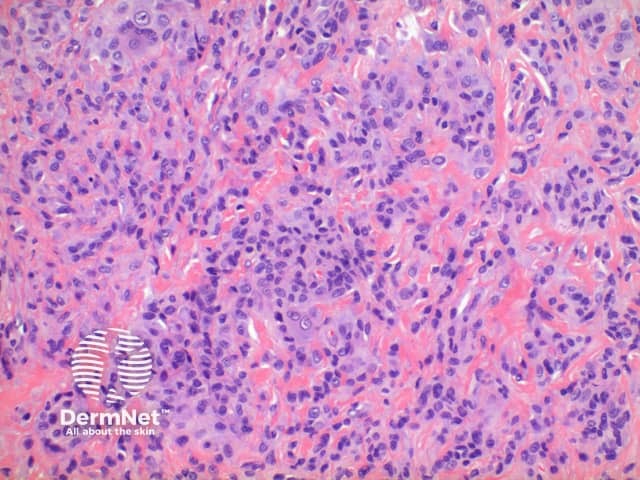
Figure 5
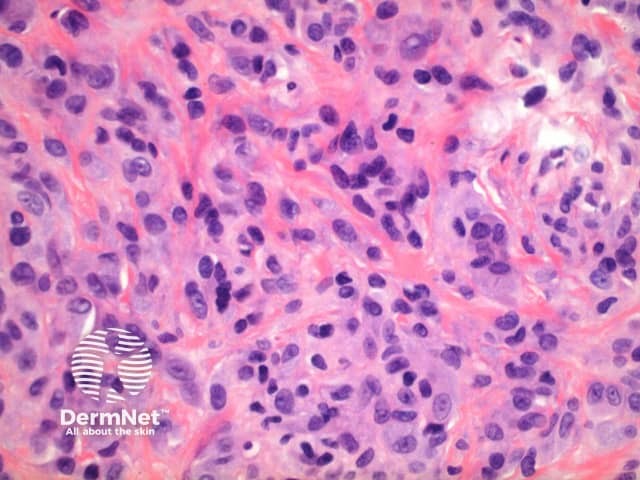
Figure 6

Main menu
Common skin conditions
NEWS
Join DermNet PRO
Read more
Quick links
Lesions (benign) Diagnosis and testing
Author: Dr Ben Tallon, Dermatologist/Dermatopathologist, Tauranga, New Zealand, 2011.
This tumour is grouped within the benign mesenchymal tumours.
Scanning power view of giant cell tumour of tendon sheath identifies a well circumscribed tumour nodule arising in the deep dermis or subcutis (Figures 1-3). The tumour nodule is comprised of a population of oval cells set in a minor condensed eosinophilic fibrous stroma (Figures 4 and 5). Scattered multinucleated giant cells are present (Figure 6). In most cases small clusters of lipid laden cells can be seen (Figures 7 and 8) .

Figure 1

Figure 2

Figure 3

Figure 4
Figure 5
Figure 6

FIgure 7

Figure 8
Giant cell tumour cells stain positively for CD68 and Vimentin suggesting a fibrohistiocytic origin.
Giant cell tumour of soft tissue: This tumour is typically a larger multinodular tumour. There may be notable stromal vasculature and deposits of metaplastic bone. Special stains can be positive for both smooth muscle actin and alkaline phosphatase, not typically seen in giant cell tumour of tendon sheath.